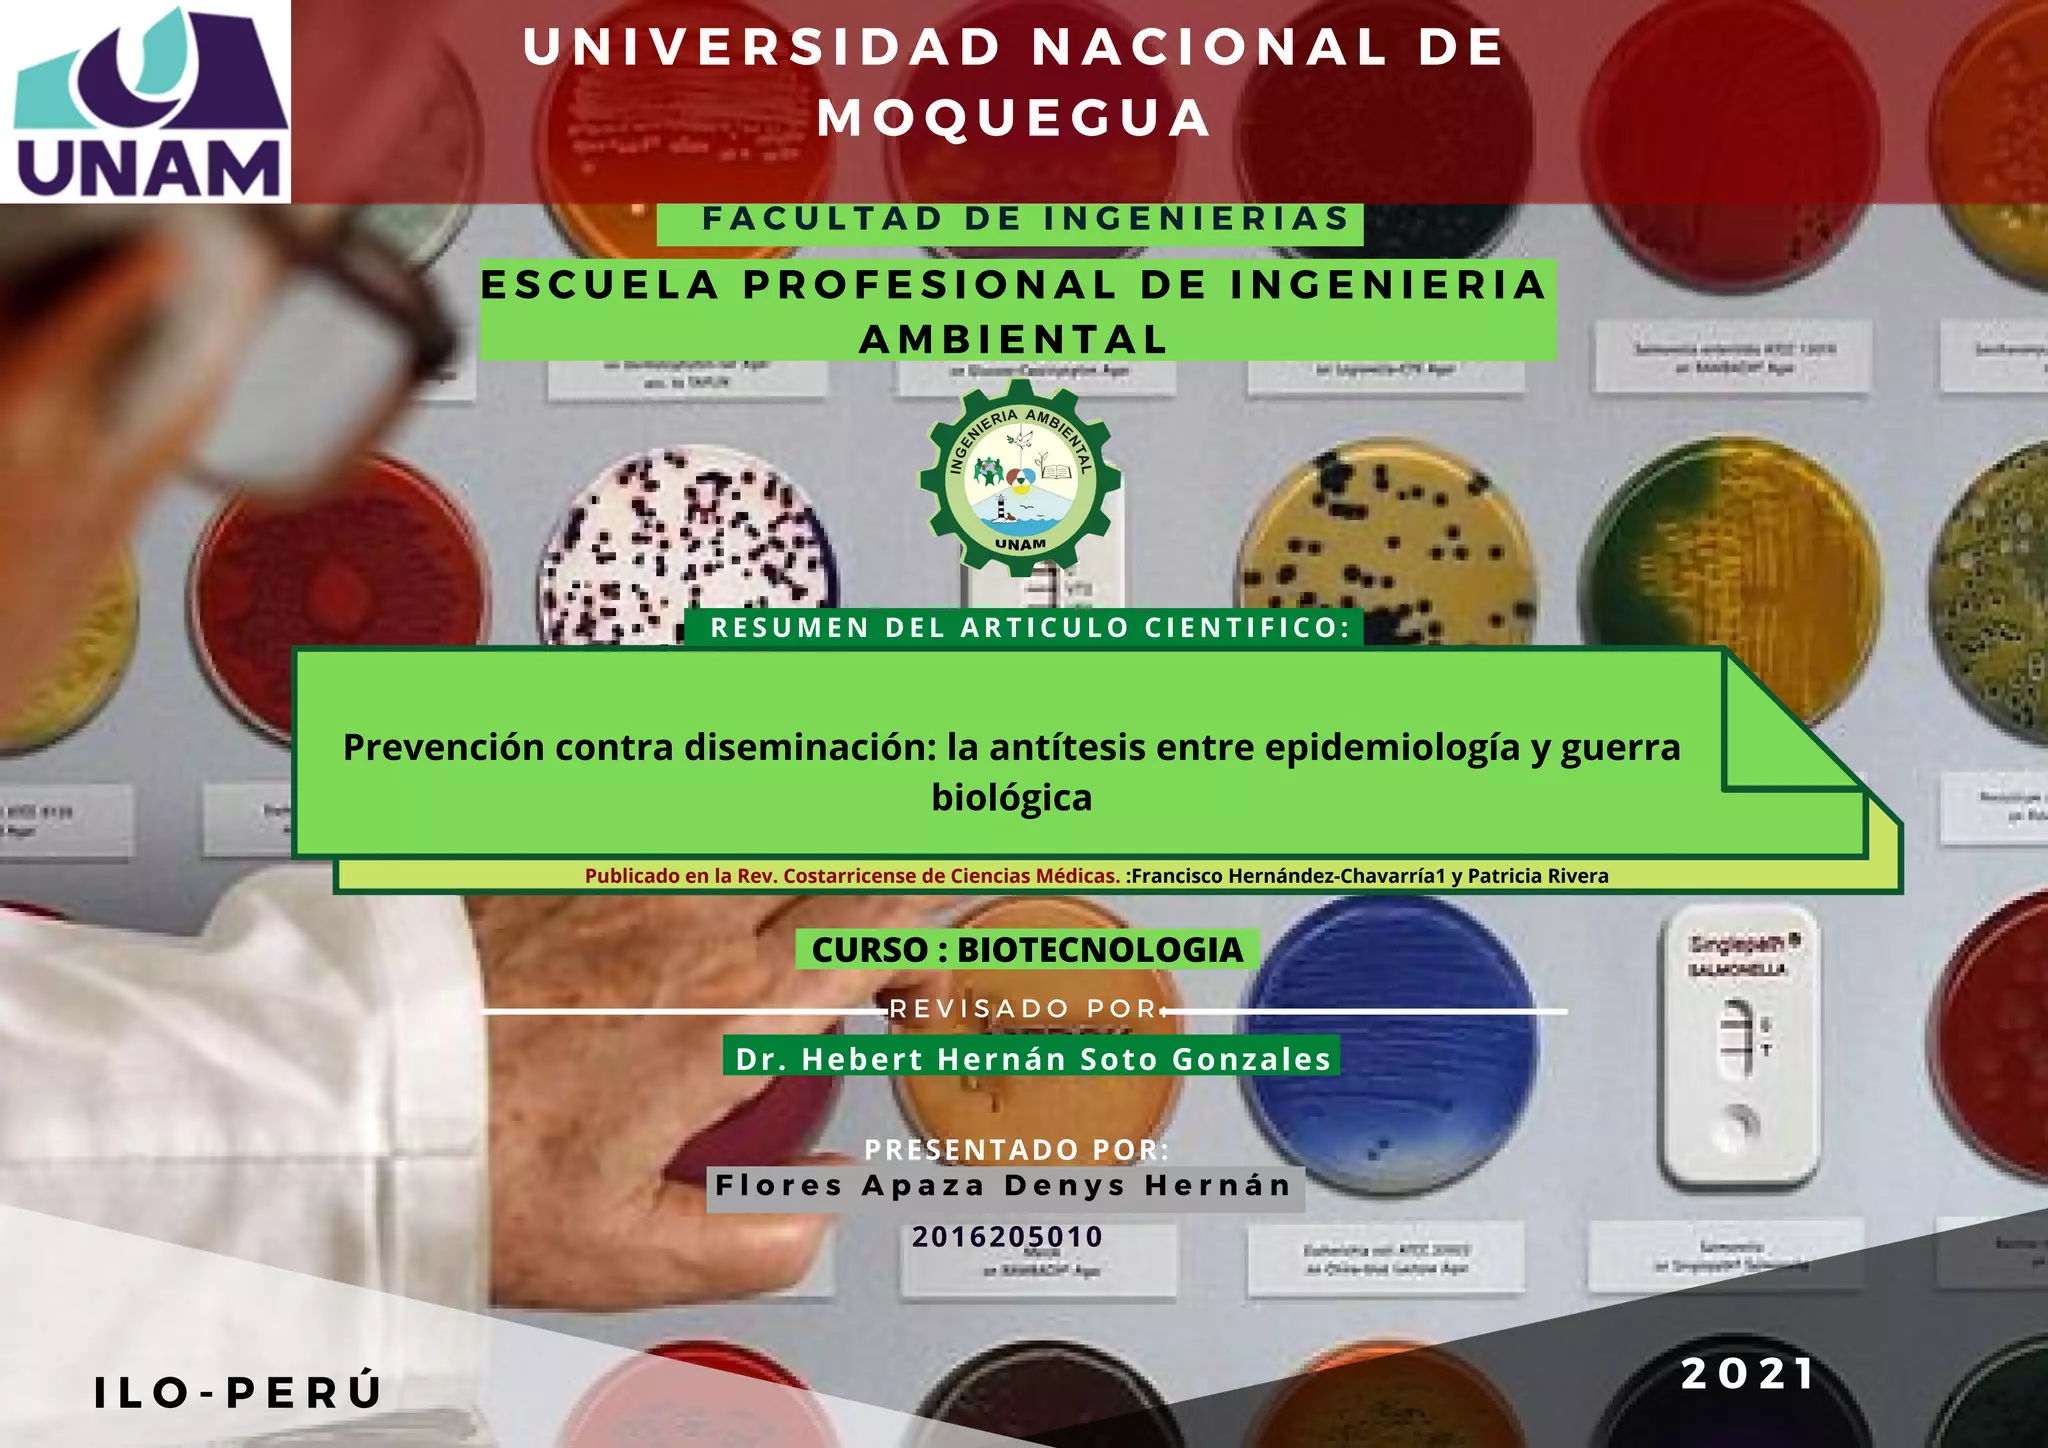

El documento resume un artículo científico sobre la prevención de enfermedades a través de la epidemiología y los riesgos que plantea el uso de agentes biológicos con fines de guerra o terrorismo. Describe algunos ejemplos históricos de ataques con armas biológicas y clasifica los posibles agentes que podrían usarse como tales. También analiza el bioterrorismo como amenaza actual y los esfuerzos de vigilancia epidemiológica.
![E l o b j e t i v o m á s
r e l e v a n t e d e l a
e p i d e m i o l o g í a
E s l a p r e v e n c i ó n
y e l c o n t r o l d e l a s
e n f e r m e d a d e s
E n p o s d e
e s t e f i n
O r g a n i s m o s v i v o s
U s u a l m e n t e a g e n t e s
i n f e c c i o s o s
s o n
P u e d e n s e r u t i l i z a d o s
c o m o
L o s a g e n t e s b i o l ó g i c o s i d e a l e s p a r a s e r
e m p l e a d o s c o m o a r m a s s o n l o s q u e p u e d e n
d i s e m i n a r s e v í a a é r e a o m e d i a n t e
c o n t a m i n a c i ó n d e a g u a s y a l i m e n t o s
E l p r o g r a m a a l e m á n f i l e
A n t e e s t o s e
d e s a r r o l l a n S i s t e m a s
d e a l e r t a :
E l b i o t e r r o r i s m o
P a s a n d e s a p e r c i b i d o s
s u r g e n l o s
p r o b l e m a s b i o é t i c o s d e l o s
a t r o c e s e x p e r i m e n t o s
U T I L I Z A C I Ó N D E B I O E N S A Y O S P A R A L A
D E T E R M I N A C I Ó N D E C O N T A M I N A C I Ó N
E N A G U A D E R I E G O E N L A C U E N C A D E L R Í O
G R A N O B L E S
R e s u m e n I N T R O D U C C I Ó N B i o t e r r o r i s m o
¿ Q u é s o n a r m a s b i o l ó g i c a s ?
B I B L I O G R A F Í A
A l g u n o s e j e m p l o s h i s t ó r i c o s d e
a t a q u e
c o n a r m a s b i o l ó g i c a s :
A r m a s b i o l ó g i c a s , c o m o a g e n t e s
i n f e c c i o s o s , t o x i n a s y l a n u e v a
m o d a l i d a d r e p r e s e n t a d a p o r l o s
b i o r r e g u l a d o r e s
E n e l c u a l :
A l g u n o s m e d i c a m e n t o s
v a c u n a s , e t c . q u e e s t á n e n
c o n t r a d e l a a p r o b a c i ó n d e
l o s d e r e c h o s h u m a n o s
S e b u s c a e l a g e n t e
r e s p o n s a b l e y s u s
d e t e r m i n a n t e s
e p i d e m i o l ó g i c o s o f a c t o r e s
q u e c o n d i c i o n a n l a
p r e s e n t a c i ó n y f r e c u e n c i a d e
e s a e n f e r m e d a d e n
u n a d e t e r m i n a d a p o b l a c i ó n
C l a s i f i c a c i ó n d e l o s
p o s i b l e s a g e n t e s
b i o l ó g i c o s e m p l e a d o s
c o m o a r m a s :
E l b i o t e r r o r i s m o
c o m o a m e n a z a
a c t u a l :
s i g l o
X I V
l o s t á r t a r o s l a n z a b a n c o n c a t a p u l t a
l o s c a d á v e r e s d e s u s s o l d a d o s m u e r t o s
p o r l a p l a g a h a c i a l a c i u d a d s i t i a d a
L o s c o l o n o s e n N o r t e A m é r i c a
R e g a l a b a n a l o s i n d í g e n a s l a s r o p a s d e
c a m a d e l o s e n f e r m o s d e v i r u e l a
s i g l o X X
E j e c u c i ó n d e
a c t o s c r i m i n a l e s
c o n t r a l a
p o b l a c i ó n g e n e r a l
F o r m a s d e e x t e r m i n i o m a s i v o
1 . J e n i c e k M , C i é r o u x R . E p i d e m i o l o g í a : P r i n c i p i o s , t é c n i c a
y a p l i c a c i o n e s . S a l v a t E d i t o r e s S A , B a r c e l o n a . 1 9 8 7 , P R 3 9 2
[ L i n k s ]
2 . R o s e n f i e l d A , M o r s e S S . S e p t e m b e r 1 1 : T h e r e s p o n s e a n d
r o l e o f p u b l i c h e a l t h . A m e r J P u b l i c H e a l t h 2 0 0 1 ; 9 2 : 1 0 - 1 1 . [
L i n k s ]
3 . S i m o n J D . B i o l o g i c a l t e r r o r i s m . J A M A 1 9 9 7 ; 2 7 8 : 4 2 8 - 4 3 0 .
[ L i n k s ]
4 . K h a n A S , M o r s e S , L i l i b r i d g e S . P u b l i c - h e a l t h
p r e p a r e d n e s s f o r b i o l o g i c a l t e r r o r i s m i n t h e U S A . L a n c e t
2 0 0 0 ; 3 5 6 : 1 1 7 9 - 1 1 8 2 . [ L i n k s ]
5 . M M W R . U p d a t e : l n v e s t i g a t i o n o f b i o t e r r o r i s m o - r e l a t e d
i n h a l a t i o n a l a n t h r a x . C o n n e c t i c u t 2 0 0 1 . M o r b M o r t a l W k l y
R e p 2 0 0 1 ; 5 0 : 1 0 4 9 - 1 0 5 1 . [ L i n k s ]
6 . M M W R . U p d a t e : A d v e r s e e v e n t s a s s o c i a t e d w i t h a n t h r a x
p r o f h y l h a x i s a m o n g p o s t a l e m p l o y e e s - N e w Y e r s e y ,
N e w Y o r k C i t y , a n d t h e D i s t r i c t o f C o l u m b i a m e t r o p o l i t a n
a r e a . M o r b M o r t a l W k l y R e p 2 0 0 1 ; 5 0 : 1 0 5 1 - 1 0 5 4 . [ L i n k s ]
7 . M a d e s e n J M . T o x i n s a s w e a p o n s o f m a s s d e s t r u c t i o n . A
c o m p a r i s o n a n d c o n t r a s t w i t h b i o l o g i c a l - w a r f a r e a n d
c h e m i c a l - w a r f a r e a g e n t s . C l i n L a b M c d 2 0 0 1 ; 2 1 : 5 9 3 - 6 0 5 . [
L i n k s ]
E s t a b l e c i d o p o r e l
g o b i e r n o d e l o s
E s t a d o s U n i d o s
. E l p r i m e r a c t o s e
r e l a c i o n ó c o n l a
c o n t a m i n a c i ó n
r e p e t i d a y
d e l i b e r a d a d e l a
b a r r a d e e n s a l a d a s
d e d o s r e s t a u r a n t e s
e n D a l l a s
C a t e g o r í a A
C a t e g o r í a B :
C a t e g o r í a C :
E m p l e a r o n c e p a s d e B a c i l l u s
a n t h r a c i s y B u r k h o l d e r i a
P s e u d o m o n a s ) m a l l e i p a r a
i n f e c t a r l o s h a t o s d e g a n a d o
q u e s e e x p o r t a b a n h a c i a R u s i a
S e t r a n s m i t e d e
p e r s o n a a p e r s o n a
A g e n t e s c o n
c a p a c i d a d m o d e r a d a
p a r a d i s e m i n a r s e
a g e n t e s e m e r g e n t e s o
q u e p u e d e n s e r
m o d i f i c a d o s m e d i a n t e
i n g e n i e r í a g e n é t i c a](https://image.slidesharecdn.com/biotecnologiabioterrorismo-210131213206/85/Biotecnologia-bioterrorismo-2-320.jpg)